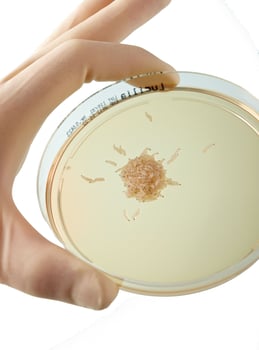
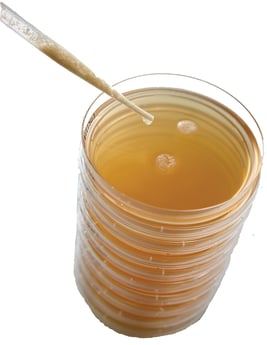

Biochirurgie/Larvothérapie
(Commande ci-dessous)
Larvothérapie - Le scalpel biologique
Qu'est-ce qu l'on entend par larvothérapie?
Le terme "larvothérapie" ou "asticothérapie" désigne l'utilisation de larves, plus précisément de larves de la mouche Lucilia sericata, pour enlever des tissus morts et dépôts (fibrineux) sur les
surfaces des plaies (débridement). En raison de sa nature biologique et de sa sélectivité pour les tissus morts, cette thérapie est également appelée biochirurgie ou débridement des zones
limitrophes.
De nos jours, la larvothérapie est de plus en plus utilisée pour répondre aux défis croissantes posés par les bactéries multi-résistantes, fréquentes dans les plaies chroniques.
Applications
- débridement de plaies chroniques stagnantes
- ulcères veineux
- plaies diabétiques
- plaies chirurgicales déhiscentes
- escarres
Mode d'action
Favorise la cicatrisation des plaies par
- un débridement sélectif, efficace et rapide (nécrolyse)
- une détersion douce, en particulier chez les patients ne pouvant être mis sous anesthésie
- une réduktion de la charge bactérienne
- la favorisation de la granulation
- les sécrétions des larves qui inhibent le développement des bactéries
plus d'infos sur
Notice d'emballage
Séquence de l'émission du 20 juin 2017
RTS
plus d'infos sur Biochirurgie.ch
Commande de larves
Les traitements sont possible de mardi à samedi (sauf jours feriés).
Commandes pour le prochain jour doivent être éffectuées jusqu‘à 14h30 au plus tard).
Tél.: +41 56 418 80 80
mail: info(at)medicalsol.ch
